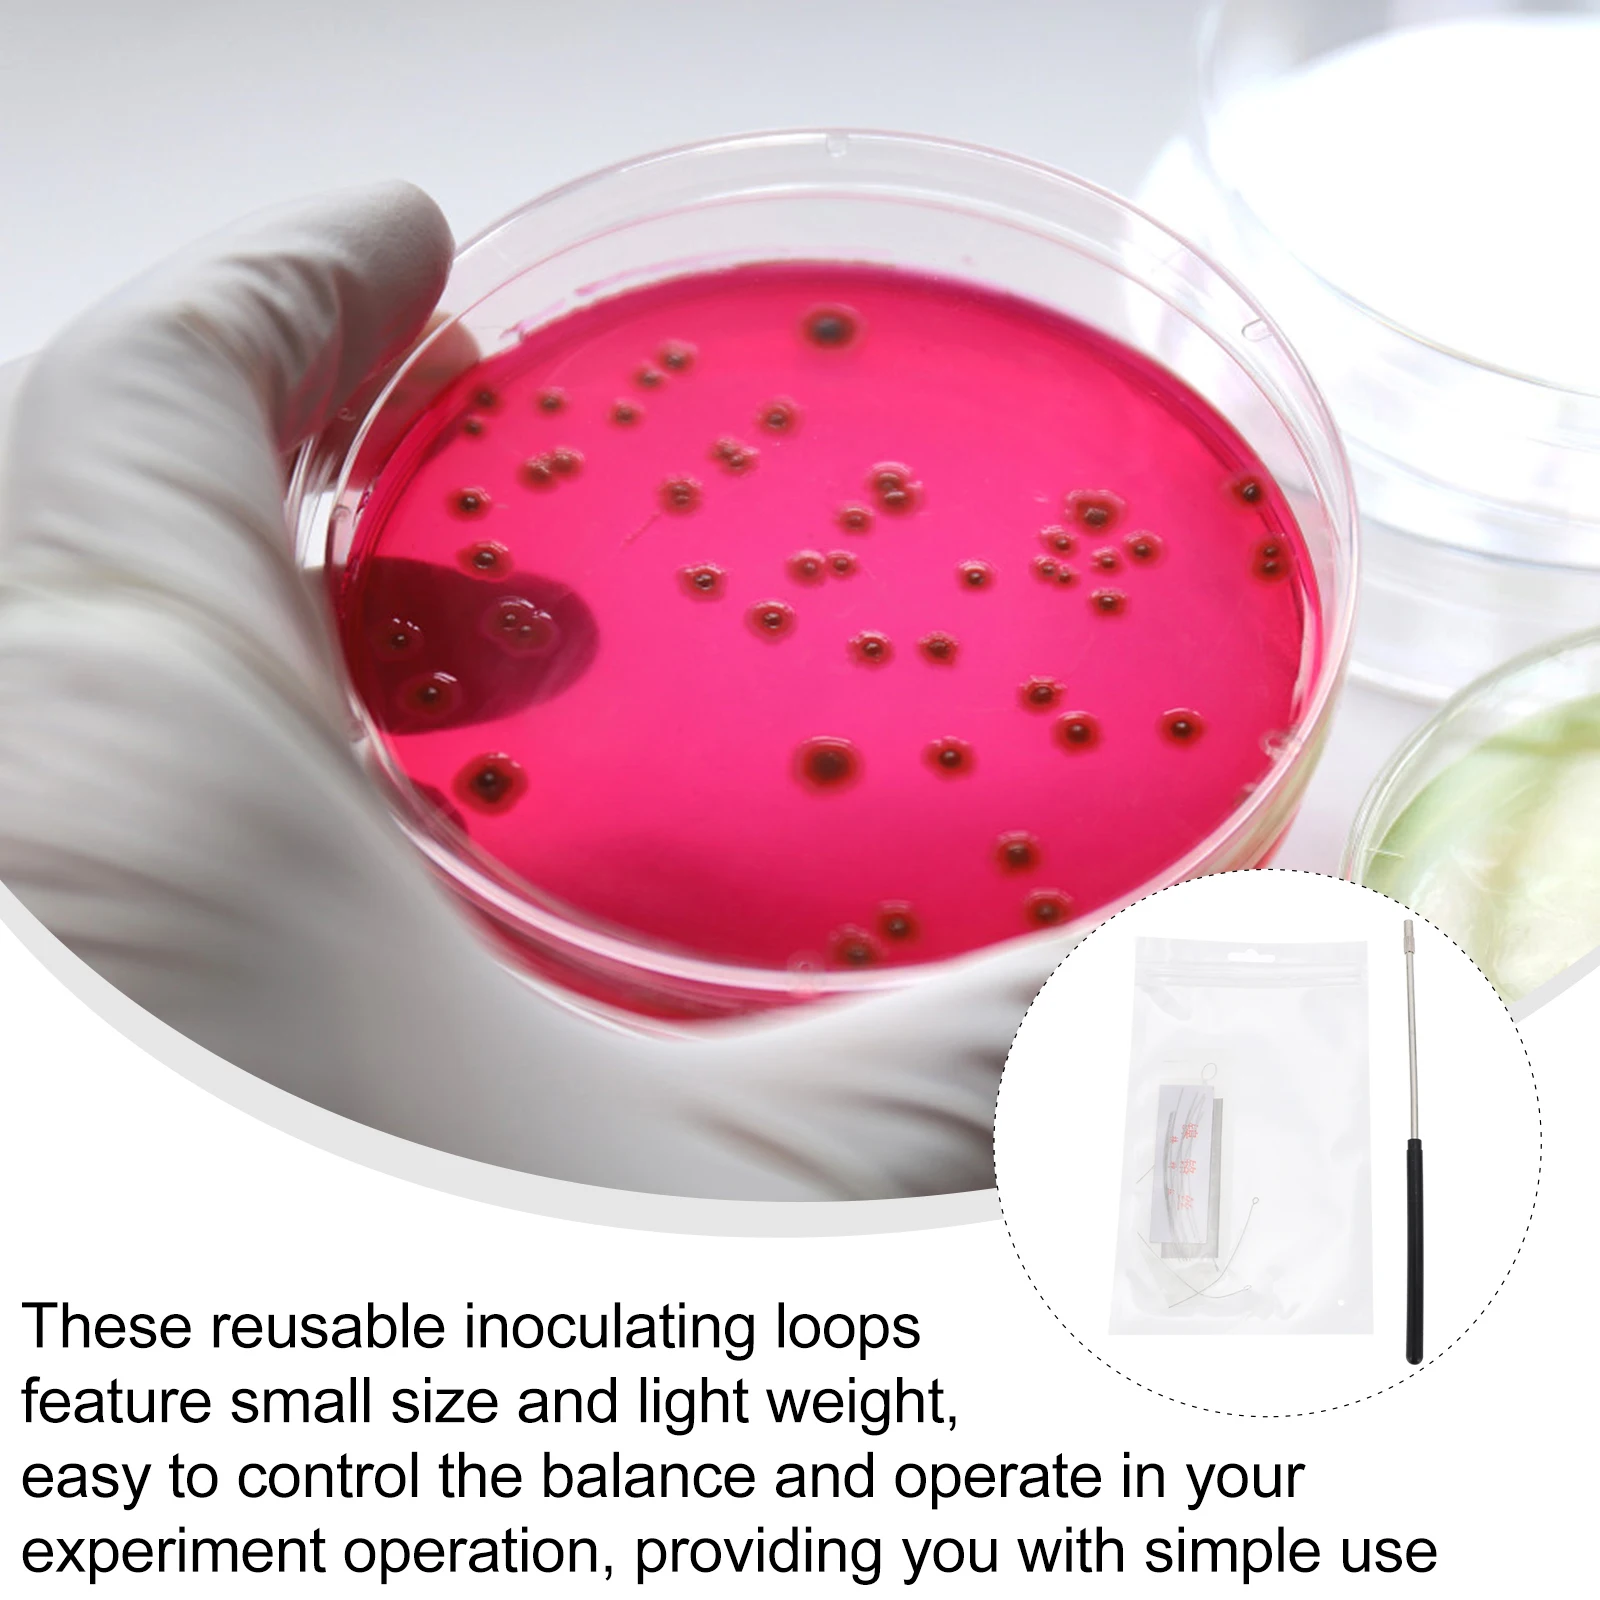

TS200 Кухонные весы Электронные весы Бытовые Малые весы Весы для выпечки Измерительные весы Прецизионные электронные весы 10Kg белый
Price history chart & currency exchange rate
Customers also viewed

2,345.54 руб.
18213-65J00, выпускной коллектор Lambda, кислородный датчик для SUZUKI GRAND VITARA
aliexpress.ru
12,508.21 руб.
Статуэтка из искусственной смолы для мини-людей, оригинальное украшение для сна, эстетическое украшение, отличная идея для подарка на День святого Валентина
aliexpress.ru
1,237.54 руб.
Grimm's fairy-tale witch T-Shirt funnys summer clothes oversized t shirts for men
aliexpress.ru
13,723.56 руб.
MSI GeForce RTX 2060 VENTUS XS OC 6144MB (RTX 2060 VENTUS XS 6G OC FR) Factory Recertified
telemart.ua![Зубило Зубр SDS-plus Эксперт 250 мм 4 шт для перфораторов [29360-H4], Зубило Зубр SDS-plus Эксперт 250 мм 4 шт для перфораторов 29360-H4
Зубило Зубр SDS-plus Эксперт 250 мм 4 шт для перфораторов [29360-H4], Зубило Зубр SDS-plus Эксперт 250 мм 4 шт для перфораторов 29360-H4](http://imarket.by/upload/iblock/6c2/6c25d20ad8388a7607273bb50bb4afe2.jpg)
1,921.69 руб.
Зубило Зубр SDS-plus Эксперт 250 мм 4 шт для перфораторов [29360-H4], Зубило Зубр SDS-plus Эксперт 250 мм 4 шт для перфораторов 29360-H4
imarket.by
292.48 руб.
Torch 300 Lumens Front Flashlight USB Rechargeable Bike Light Cycling Accessories Headlight Front Rear Taillight
aliexpress.ru
168.64 руб.
Marvel Spiderman Cartoon Art For Xiaomi Redmi Note 11 10S 10 9S 9T 9 8T 8 Pro Plus 7 6 5 4G 5G Liquid Left Rope Soft Phone Case
aliexpress.ru
280.26 руб.
You Are Toadally Awesome New Metal Cutting Dies Stamps For 2022 Scrapbook Diary Decoration Embossing Template Diy Greeting Card
aliexpress.ru
406.54 руб.
Уличный тренд в классическом ретро-стиле с коротким рукавом в европейском и американском стиле мужская повседневная Однотонная футболка с ...
aliexpress.ru
2,607.07 руб.
Sit-ups And Leg Hooks K261-1 Wall Hook Frame Waist And Back Muscle Training Belly-Crunching Aids Home Fitness Equipment
aliexpress.com
2,418.05 руб.
Portable 304 Stainless Steel Lunch Box Creative Sealed Lid Handle Lunch Box Student Office Worker Lunch Box Food Container
aliexpress.com
1,292.94 руб.
For AirPods Pro /airpod 3/AirPods 2 Case Cute Korean Bear Flower Tulip Pendant Headphone Case Air Pods 3 Silicone Earphone Cover
aliexpress.ru
623.25 руб.
Large Capacity Pencil Cases Double Zipper Kawaii Macaron Korean Style Boxes Pouch Holder for Girls School Supplies Stationery
aliexpress.com
751.98 руб.
Women Bodycon Dress Satin Mini Dress Summer Elegant Dresses Woman Party Night Sexy Backless Slim Fit Midi
aliexpress.ru
198.79 руб.
10pcs 194 W5W T10-3014-24SMD LED Tail Bulb Brake Lights Auto Reverse Lamp Daytime Running Signal Light
aliexpress.ru
248.49 руб.
Cartoon Astronaut Case For Iphone 7 Plus Case IPhone 11 Pro Max Full Package Cover Iphone 12 Mini 13 XS 8 SE 2022
aliexpress.ru
1,829.02 руб.
Адаптер Co2 для Sodastreama-60 дюймовый адаптер Co2 для заправки CGA320 адаптер шланг с аксессуарами
aliexpress.ru
1,235.10 руб.
15 Pcs Bath Panel Clips Heavy Duty Kitchen Kick Board Plinth Clips Kickboard Brackets For Kitchen Cabinets Bed Legs
aliexpress.com
1,151.18 руб.
2 Set For JLB Racing CHEETAH 1/10 Brushless RC Car Parts Accessories, Bumper Set & Ball Head Screw 8X22mm
aliexpress.com
3,721.59 руб.
Car AFS Headlight Ballast Lamp Cornering Control Module For - A3 For Skoda For Golf 7L6941329B
aliexpress.com
492.90 руб.
Motorcycle Universal LED Signal Light Wing Shape Daytime Running Lights Double Flowing Flasher Indicator
aliexpress.com
615.92 руб.
Для 2016-2019 с леопардовым принтом XE XF E-Pace подходит для Jaguar XF F-Pace подходит для Jaguar XF Range Rover велар (Land Rover Range Rover подножка Сталь подставка для ног н...
aliexpress.com
63.55 руб.
NEW EVA Fashion Comfort Wrist Support Non-slip Mouse PadNotebook Computer Gaming Mouse Protective Pad To Relieve Arm Fatigue
aliexpress.com
2,235.30 руб.
Комплект постельного белья NSHV Евро Бязь Черный с голубым однотонный постільна білизна n_4106ev
allo.ua
386.17 руб.
Glass Bottled Smooth Writing Fountain Pen Non-carbon Ink Refill Stationery School Supplies
aliexpress.com
3,026.64 руб.
38MM-51MM Universal Motorcycle Accessories Muffler Exhaust Pipe for Kawasaki ZRX1100 1200 ZX1100 ZX11 VERSYS 650cc ZG1000
aliexpress.com
883.96 руб.
30Pcs PCT-218 PCT218 222-418 Universal Compact Wire Wiring Connector Connectors 8 pin Conductor Terminal Block With Lever
aliexpress.com
578.44 руб.
1 Set 3D Permanent Eyebrow Tattoo Practice Kit/set Microbladings Pen Tattoo Pigment Makeup Beauty Tools #F
aliexpress.com